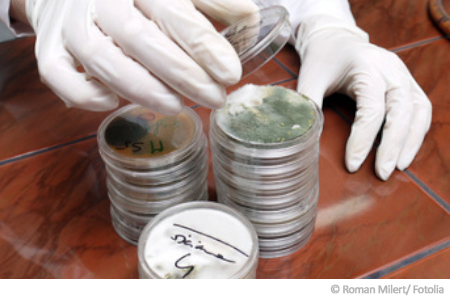

Die Schimmelpilzmessung: verlässlicher Marker für Ihre Raumluftqualität
▷ Wussten Sie, dass Schimmelpilze allgegenwärtig und für die Umwelt von wichtiger Bedeutung sind?
Die elementare Relevanz kommt beispielsweise bei der Zersetzung von Tothölzern zum Tragen.
Ebenso
hat der Mensch sich die positiven Eigenschaften des Schimmels zunutze
gemacht: Die geschätzte kulinarische Seite des Schimmelpilzes erschließt
sich in Lebensmitteln wie Edelschimmelkäse.
❕
Gefürchtet wird der Schimmelpilz hingegen in der Raumluft, sind seine
Sporen doch unsichtbar und somit mit bloßem Auge nicht nachweisbar.
Aufschluss über eine eventuelle Belastung Ihres Zuhauses gibt eine Schimmelpilzmessung.
Ihr Schimmel Gutachter steht Ihnen hierbei mit Rat zur Seite.
➽ Jetzt hier klicken für Ihren Schimmel Gutachter!
Bei der professionellen Schimmelpilzmessung werden Anzahl und Gattung der Schimmelpilzsporen in Ihrer Raumluft sowie in der Außenluft per Labordiagnostik
untersucht. Bei bereits sichtbarem Schimmelpilzbefall wird eine
Abklatschprobe zur mikrobiologischen Analyse genommen. Wenn Sie die
Raumluft testen, möchten wird eine Raumluftprobe entnommen.
Hierfür stellt man eine Petrischale mit Nährboden für ca. 2 Stunden im Raum auf.
Diese Proben werden im Labor dann auf die Schimmelpilzgattung untersucht.
Anhand dieser Werte kann Ihnen Ihr Schimmel Gutachter genau sagen, wie Sie vorgehen sollten und welche Schritte umgesetzt werden sollten.
Was sind Schimmelpilze?
Betrachten wir zunächst einmal, worum es sich bei Schimmelpilzen handelt beziehungsweise welche Eigenschaften sie aufweisen:
- Schimmelpilze
bilden arttypische Pilzfäden sowie nur unter dem Mikroskop erkennbare
Sporen. Es sind derzeit über 100.000 Schimmelpilzarten bekannt. Alle Schimmelpilzsporen weisen allergene Strukturen auf.
- Schimmelpilze können über Jahre auch in trockenem Raumklima überleben. Ein Wachstum ist jedoch nur bei Feuchtigkeit möglich.
- Aufgrund ihrer wichtigen Rolle in der Zersetzung von organischem Material sind sie im Boden sowie in der Luft praktisch allgegenwärtig.
Wie kommt der Schimmel in die Raumluft?
Durch
die allgegenwärtige Präsenz von Schimmel kann dieser überaus leicht in
Ihren Wohnraum gelangen. Trifft er hierbei auf Feuchtigkeit, steht einem
Wachstum nichts mehr im Wege.
Gesundheitlich bedenklich kann
eine hohe Belastung an Pilzsporen in der Raumluft besonders dann werden,
wenn bereits Atemwegserkrankungen wie Asthma bronchiale oder
Autoimmunerkrankungen wie Multiple Sklerose vorliegen. Bei
Immunsuppression, also Gabe von Glukokortikoiden wie Cortison, erhöht
sich das Gesundheitsrisiko durch Schimmelbefall. Auch für gesunde
Menschen ist Schimmel jedoch nicht unproblematisch, wie wir nachfolgend
sehen werden.
Scheuen Sie sich somit nicht, einen kompetenten Schimmel Gutachter für eine individuelle Schimmelpilzdiagnostik zurate zu ziehen. Neben
der beschriebenen Schimmelpilzmessung kann bei nachgewiesener Belastung
eine fachgerechte Schimmelpilzbeseitigung veranlasst werden.
Für mehr Wohlbefinden in den eigenen vier Wänden!
Schimmel in Wohnräumen: Ein allgemeines Gesundheitsrisiko?
Die WHO verweist in ihren Leitlinien klar auf eine negative gesundheitliche Beeinflussung durch kontaminierte Wohnräume.
Themenrelevante Studien zeigen hierbei auf, dass eine Gesundheitsgefährdung durch Schimmelsporen in der Raumluft auch für gesunde Menschen besteht.
Eine Schimmelpilzdiagnostik mit entsprechender Schimmelpilzbeseitigung kann sich somit nachhaltig regulierend auf Ihr Wohlbefinden auswirken.
Um
eine Gefährdung durch unsachgemäße Entfernung zu vermeiden, empfiehlt
es sich ausdrücklich, die Schimmelpilzbeseitigung nach erfolgter
Schimmelpilzmessung vom Fachmann durchführen zu lassen.
Innenraumbelastung durch Schimmelsporen: länderspezifische Problematik?
Ein interessanter Fakt zur Schimmelbelastung in Wohnräumen:
Eine
entsprechende Kontamination variiert sowohl innerhalb von Ländern als
auch zwischen Ländern, Klimazonen und Kontinenten deutlich.
Offizielle
Schätzungen legen dar, dass 10-50 % der Innenräume in Australien,
Europa, Indien und Japan von einer hohen Schimmelsporenbelastung
betroffen sind.
Hierbei ist die Belastung in wassernahen
Wohnräumen wie zum Beispiel an Flüssen oder in Küstengebieten im
Allgemeinen deutlich höher als im nationalen Durchschnitt.
Ihr Zuhause ist in einem der erwähnten Gebiete angesiedelt?
Trifft dies zu, so ist eine Schimmelpilzmessung klar empfehlenswert.
Gerne stehen wir Ihnen hierbei kompetent mit Rat und Tat zur Seite!
➽ Jetzt hier klicken für Ihren Schimmelpilz Experten!
✔️ Bis zu 6 Räume
✔️ Original airself
✔️ 1 Laboranalyse
✔️ Original airself
✔️ 1 Laboranalyse
✔️ Raumluft/Abklatsch